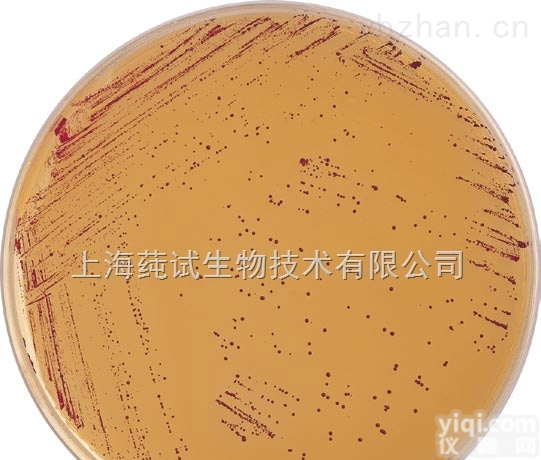
dragon牙膏稀释<em>缓冲</em>液<em>售后服务</em>

贵州1吨缓冲电子称多少钱/售后服务
- 型号:SCS
- 产地:中国大陆
- 供应商:上海仪展衡器有限公司
- 供应商报价:电议
- 标签:贵州1吨缓冲电子称多少钱/售后服务,计量仪器,力学计量,供应贵州1吨缓冲电子称多少钱/售后服务,上海仪展电子秤有限公司
贵州1吨缓冲电子称多少钱/售后服务
仪展专业生产:(1吨,2吨,3吨,5吨,10吨,15吨,20吨,30吨)缓冲电子秤,缓冲地磅秤,缓冲秤,缓冲电子磅秤厂家,缓冲地磅称价格,缓冲地磅秤价钱
联系人: 颜小姐
业务手机:
业务QQ: 2295319627
传真:
公司网站:http://www.hengqic.com/
地址:上海市浦东新区周祝公路2701号
电子缓冲秤性能:
……该电子秤采用三层秤台
……高性能缓冲避震装置吸收加载时的冲击能量
……配套使用高精度剪切梁式称重传感器和智能化称重仪表
……量程2t-30t,双秤秤体
……整体框架,移动方便
……高性能缓冲避震装置
……结构简单、安装、维护方便、精度高、长期稳定性好
……可根据客户要求任意定做
缓冲秤,缓冲称,缓冲型电子磅,缓冲地磅
产品名称:缓冲秤
原理:适用于有强烈冲击的称重场合,利用螺旋弹簧作缓冲器,结构简单实用,减震效果极好,弾簧减震器寿命高达30年以上,无需维修,本产品设计克服了弹簧共振现象对称重稳定时间的影响,台面尺寸及秤量任选
适用范围:特别使用起吊设备搬运货物计量,能有效吸收称量过程中货物的冲击力。广泛适用于冶金、建材、仓储货运、内河码头等行业具有强烈冲击的称重场合。
缓冲地磅称特点:
……该电子缓冲秤采用三层秤台
……高性能缓冲避震装置吸收加载时的冲击能量
……配套使用高精度剪切梁式称重传感器和智能化称重仪表
……该秤抗冲击、耐疲劳、准确度高,工作稳定可靠
……量程2t-30t,双秤秤体
……整体框架,移动方便
……高性能缓冲避震装置
……结构简单、安装、维护方便、精度高、长期稳定性好
……利用螺旋弹簧作缓冲器,结构简单实用,减震效果极好
……弾簧减震器寿命高达30年以上,无需维修
……本产品设计克服了弹簧共振现象对称重稳定时间的影响
……本产品明显优于把橡胶或压缩空气作为缓冲器的衡器
……大量的应用案例证明了其结构的合理性
……台面尺寸及秤量任选
缓冲磅秤,缓冲地磅,缓冲电子秤价格适用于有强烈冲击的称重场合,利用优质螺旋弹簧作缓冲器,能有效吸收称量过程中货物的冲击力。广泛适用于冶金、建材、仓储货运、内河码头等行业
电子缓冲秤特点:
电子缓冲秤采用三层秤台,高性能缓冲避震装置吸收加载时的冲击能量,配套使用高精度剪切梁式称重传感器和智能化称重仪表。双秤台内装有高强度缓冲弹簧,防冲击、提高传感器使用寿命。广泛适用于冶金、建材、仓储货运、码头等行业。
……量程2t-30t,双秤秤体
……整体框架,移动方便
……高性能缓冲避震装置
……结构简单、安装、维护方便、精度高、长期稳定性好
电子缓冲秤性能:
……高精度A/D转换,可读性达1/6000
……调用内码显示方便,替代感量砝码观察及分析允差
……特殊的软件技术,增强系统的抗振动能力
……零位跟踪范围、置零(开机/手动)范围、可分别设置
……数字滤波的速度、幅度以及稳定的时间可设置
……多种背光模式可选择
……可随机充电;具有欠压指示及保护装置
……随机配置6V/4AH免维护蓄电池
……选配RS-232通讯口,波特率可选,通讯方式可选
……选配20mA电流环大屏幕通讯口
贵州1吨缓冲电子称多少钱/售后服务 仪展实行全国各地发货: 海南、湖北、湖南、广西、广东、河南、河北、山东、山西 、江苏、浙江、江西、黑龙江、新疆、云南、贵州、福建、吉林、安徽、 四川、西藏、宁夏、辽宁、青海、甘肃、陕西、内蒙古、重庆、北京、上海、天津等
电子缓冲秤技术参数:
……称重精度:III(GB/T7723-2002)
……显示模式:6LED显示,字高20mm
……环境温度:传感器:-20 - +40度
……称重仪表:- +40度
……环境湿度:<90% RH,无凝露
……电缆长度:5m信号电缆
……电源电压:AC 220V+10%,50Hz。DC 6V4Ah
……工作时间:充电一次,可连续工作30h
……额定功率:<5W
……保护措施:智能判别电池电量,自动关机
……通讯接口:Rs 232c可连接打印机或电脑
嘉定区 宝山区 青浦区 金山区 闵行区 松江区 奉贤区 南汇区 浦东新区(工业区) 普陀区 长宁区 卢湾区 徐汇区 闸北区 虹口区 杨浦区 黄浦区 晋安区 崇明岛
贵州1吨缓冲电子称多少钱/售后服务